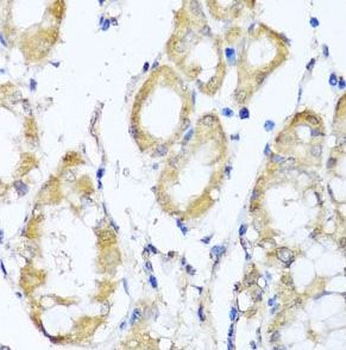
KCND2 Antibody

You have no items in your shopping cart.
Cart summary

KCND2
Catalog Number: orb528638
Product Properties
| Catalog Number | orb528638 |
|---|---|
| Category | Tools |
| Description | KCND2 |
| Form/Appearance | 10 μg plasmid + 200μl Glycerol |
| UniProt ID | BC110449 |
| ATGGCGGCGGGGGTGGCAGCGTGGCTGCCTTTTGCAAGGGCAGCGGCTATCGGGTGGATGCCTGTGGCCTCGGGGCCTATGCCGGCTCCCCCGAGGCAGGAGAGGAAAAGGACCCAAGATGCTCTCATTGTGCTGAATGTGAGTGGCACCCGCTTCCAGACGTGGCAGGACACCCTGGAACGTTACCCAGACACTCTACTGGGCAGTTCTGAGAGGGACTTTTTCTACCACCCAGAAACTCAGCAGTATTTCTTTGACCGTGACCCAGACATCTTCCGCCACATCCTGAATTTCTACCGCACTGGGAAGCTCCACTATCCTCGCCACGAGTGCATCTCTGCTTACGATGAAGAACTGGCCTTCTTTGGCCTCATCCCGGAAATCATCGGCGACTGCTGTTATGAGGAGTACAAGGATCGCAGGCGAGAGAACGCCGAGCGCCTGCAGGACGACGCGGATACCGACACCGCTGGGGAGAGCGCCTTGCCCACCATGACTGCAAGGCAGAGGGTCTGGAGGGCCTTCGAGAACCCCCACACCAGCACGATGGCCCTGGTGTTCTACTATGTCACGGGGTTTTTCATTGCCGTCTCTGTCATCGCGAATGTGGTGGAAACAGTGCCGTGCGGATCAAGCCCAGGTCACATTAAAGAACTGCCCTGTGGAGAGCGGTATGCTGTGGCCTTCTTCTGCTTGGACACGGCCTGCGTCATGATCTTCACAGTTGAGTATTTGCTTCGCCTGGCTGCAGCGCCTAGTCGTTACCGTTTTGTGCGTAGTGTCATGAGTATCATCGACGTGGTGGCCATCCTGCCTTATTACATTGGGCTGGTGATGACAGACAATGAGGACGTCAGCGGAGCCTTTGTCACACTCCGAGTCTTCCGGGTCTTCAGGATCTTTAAGTTTTCCCGCCACTCTCAAGGCCTGCGCATCCTGGGGTACACACTGAAGAGTTGTGCCTCAGAATTGGGCTTCTTGCTTTTCTCGCTCACCATGGCTATCATCATCTTCGCTACAGTTATGTTCTACGCAGAGAAGGGGTCTTCGGCTAGCAAGTTCACCAGCATCCCTGCAGCCTTCTGGTATACCATCGTCACCATGACAACACTAGGGTATGGTGACATGGTGCCAAAAACCATAGCAGGGAAGATTTTTGGTTCTATCTGTTCGCTGAGTGGGGTCTTGGTCATTGCTCTACCTGTTCCGGTGATTGTATCCAACTTCAGTCGCATCTACCACCAGAATCAACGAGCAGACAAACGAAGGGCACAAAAGAAAGCTAGACTGGCCAGGATCCGGGCAGCCAAAAGCGGAAGCGCAAATGCTTACATGCAGAGCAAACGGAATGGTTTACTCAGTAATCAGCTGCAGTCCTCAGAGGATGAGCAGGCTTTTGTTAGCAAATCCGGCTCCAGCTTTGAAACCCAGCACCACCACCTGCTTCACTGCCTGGAAAAAACCACGAATCACGAGTTTGTGGACGAACAAGTCTTTGAAGAAAGCTGCATGGAAGTTGCAACTGTTAATCGTCCTTCAAGTCACAGTCCTTCACTGTCTTCACAACAAGGAGTCACCAGCACCTGCTGTTCACGACGACACAAAAAAACTTTTCGCATCCCAAATGCCAATGTATCAGGAAGCCATCAAGGTAGTATACAAGAACTCAGCACGATTCAGATCAGATGTGTGGAGAGAACACCTCTGTCTAACAGCCGATCCAGTTTAAATGCCAAAATGGAAGAGTGTGTTAAACTAAACTGTGAACAACCTTATGTGACTACAGCAATAATAAGCATCCCAACACCTCCAGTAACCACACCAGAAGGAGACGATAGGCCAGAATCCCCTGAGTACTCAGGAGGAAATATTGTCAGAGTTTCTGCTTTGTAA | |
| DNA Notes | pENTR223.1 |
| Note | For research use only |
Images
Similar Products
Phospho-Kv4.2 (Thr607) Rabbit Polyclonal Antibody [orb317645]
IF, IHC-Fr, IHC-P
Bovine, Human, Mouse, Porcine, Rabbit
Rat
Rabbit
Polyclonal
Unconjugated
200 μl, 50 μl, 100 μlRabbit Rat Potassium Channel Antibody [orb108691]
ICC, IF, IP, WB
Rat
Rabbit
Polyclonal
Unconjugated
100 μg
Reviews
KCND2 (orb528638)
Based on 0 reviews
Participating in our Biorbyt product reviews program enables you to support fellow scientists by sharing your firsthand experience with our products.
Login to Submit a Review